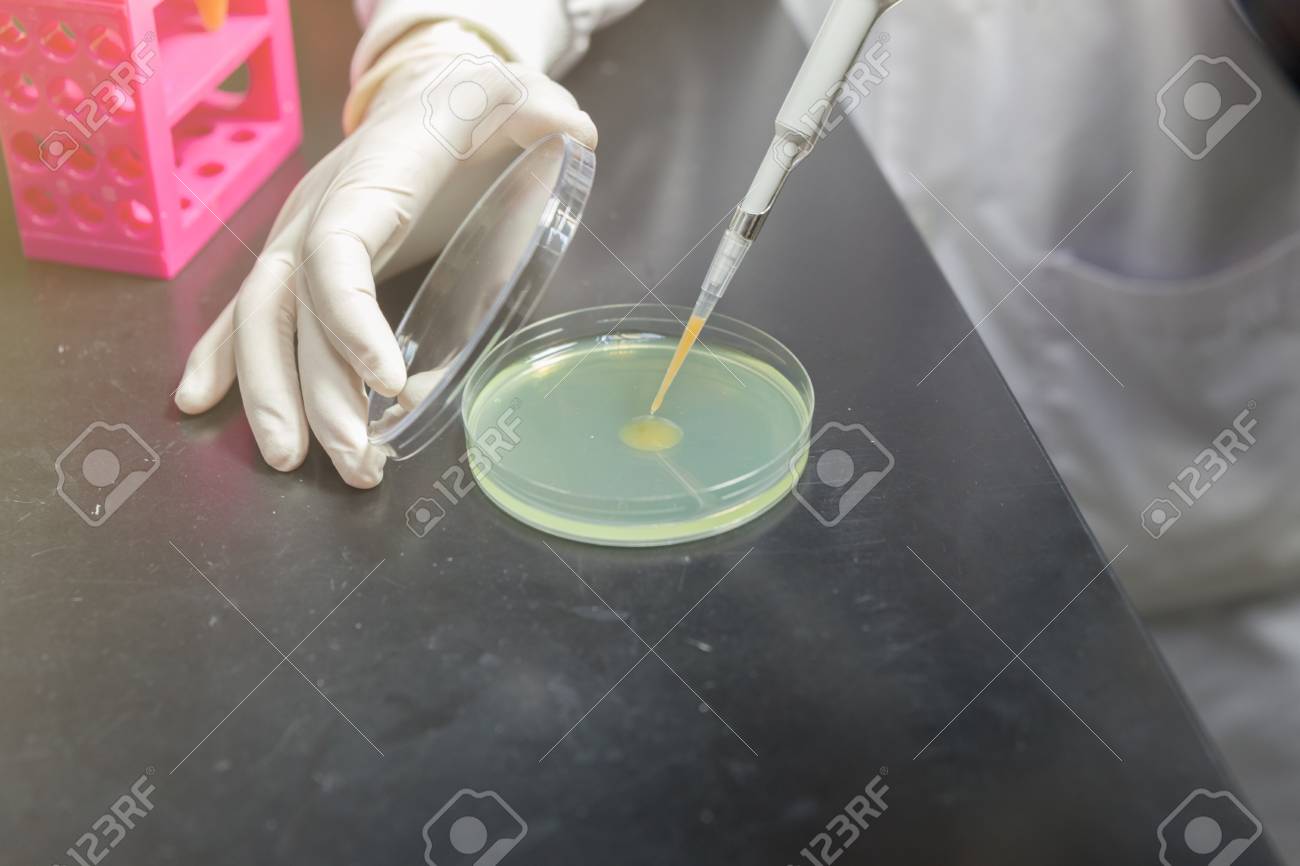

suck sample

π£ ππ»ππ»ππ» FOR MORE INFORMATION, CLICK HERE ππ»ππ»ππ»
Japanese Brazilian
Porn Service Video
Miami Latina Backpage
Amateur Porn Photo Finder
Beauties In The Shower
Panty Slip Pussy
Skinny hippie fuck
suck sample

/cdn.vox-cdn.com/uploads/chorus_asset/file/23069400/Sample_Gates_Tulips_2021_12__a9624d06_e57d_4b99_8991_44756ffc330a.jpg)


h_360">al_c">q_80">usm_0.66_1.00_0.01/Suck%20River%20Low%20Res.webp">



































